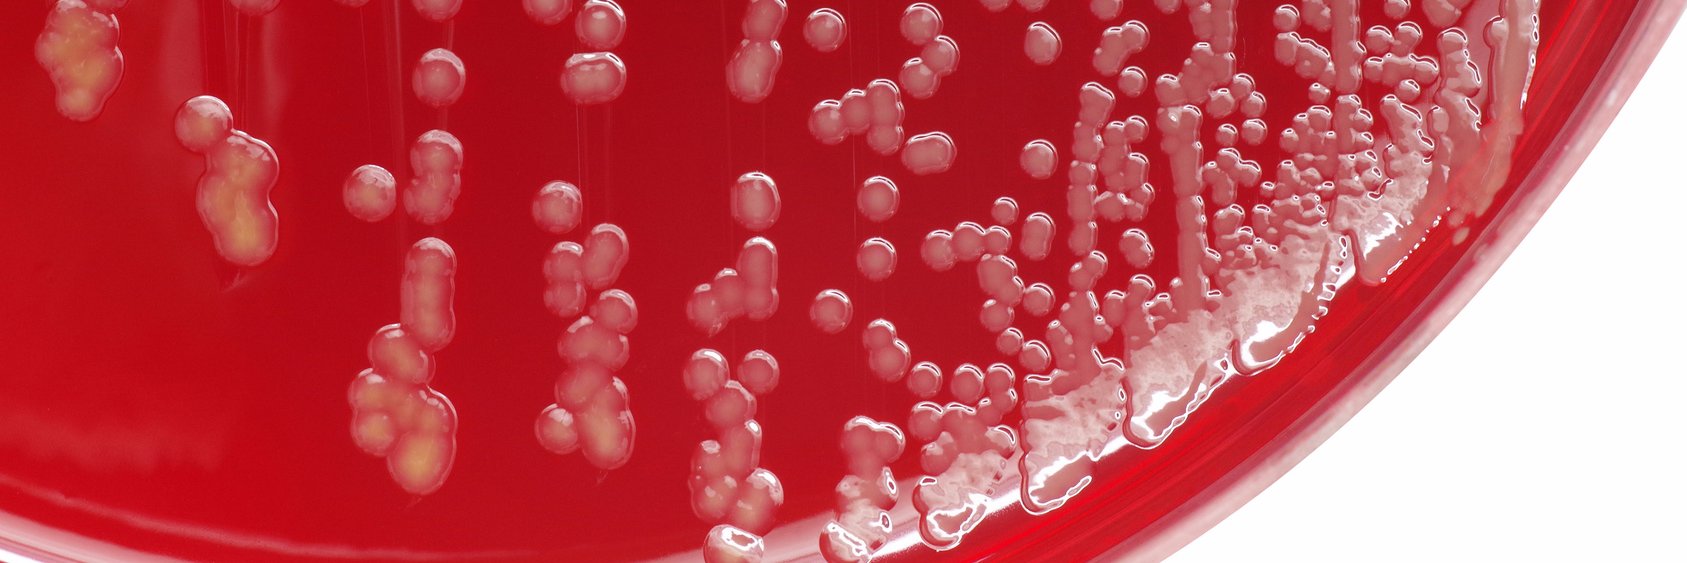
AMiCI Consortium banner

AMiCI Consortium retweetledi

We have special news for you! We are organizing a two-day online event packed with knowledge, experts, and case studies, to discover the full potential of AI in the drug discovery process.
Read more here:
linkedin.com/events/boostyo…

English